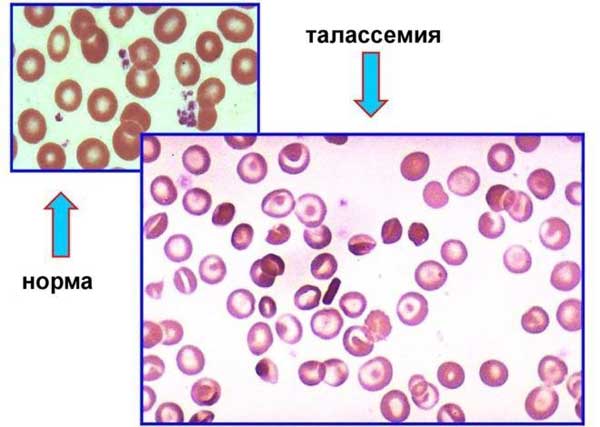
талассамия

Что такое RDW в крови
В медицине термин RDW обозначает относительную ширину распределения эритроцитов по объему. Это исследование помогает оценить разнообразие красных кровяных клеток и их размеры. RDW показывает соотношение между клетками нормального размера и теми, которые имеют отклонения.
В анализе выделяют два типа значений:
- RDW cv (процентное распределение по размеру);
- RDW sd (разница между самым большим и самым маленьким эритроцитом).
Этот показатель является ключевым для анализа состава крови и может помочь в выявлении различных патологий в организме человека.
Любое отклонение от нормы, превышающее 15 процентов, свидетельствует о наличии анизоцитоза (изменении формы эритроцитов). В нормальных условиях красные кровяные клетки имеют почти одинаковые размеры.
RDW, или индекс распределения эритроцитов, является важным показателем в анализе крови, который помогает врачам оценить разнообразие размеров красных кровяных клеток. Врачи отмечают, что нормальные значения RDW свидетельствуют о равномерном распределении эритроцитов, что обычно указывает на отсутствие анемии или других заболеваний. Однако повышенные уровни RDW могут указывать на различные патологии, такие как железодефицитная анемия или мегалобластная анемия. Специалисты подчеркивают, что RDW следует рассматривать в контексте других показателей анализа крови, таких как уровень гемоглобина и количество эритроцитов, для более точной диагностики. Таким образом, RDW является ценным инструментом для врачей в процессе диагностики и мониторинга состояния пациента.
https://youtube.com/watch?v=LMNY8M9TRKk
Диагностика
Чтобы узнать значение RDW, необходимо пройти общий анализ крови в медицинском учреждении, будь то государственная больница или частная клиника. Пациенту выдается направление на данное исследование.
Диагностика проводится в лабораторных условиях. Сначала дезинфицируют подушечку безымянного пальца, после чего выполняется прокол с помощью специальной иглы, называемой скарификатором.
Затем с помощью устройства, напоминающего пипетку, берется нужное количество крови из пальца и помещается в пробирку.
Лаборант, используя различные реагенты и микроскоп, анализирует показатели крови. Результаты анализа можно получить уже через несколько часов.
В некоторых случаях, если выявляются отклонения, пациенту может потребоваться повторный анализ крови. Обычно для этого берется биологический материал из вены, расположенной в области локтевого сгиба.
У маленьких детей забор крови осуществляется из пальца.
В процессе анализа определяется индекс распределения эритроцитов в крови. Расшифровка результатов производится квалифицированным специалистом.
Современные анализаторы, применяемые в лабораториях, обеспечивают высокую точность результатов.
| Показатель RDW | Значение | Возможные причины повышения |
|---|---|---|
| RDW (ширина распределения эритроцитов) | Измеряется в % или fL, отражает вариабельность размера эритроцитов. | Железодефицитная анемия, талассемия, анемия хронических заболеваний, дефицит витамина B12 или фолиевой кислоты, миелодиспластический синдром, после химиотерапии. |
| Нормальные значения | 11.5-14.5% (может варьироваться в зависимости от лаборатории) | — |
| Повышенные значения ( >14.5%) | Указывает на анизоцитоз (разнообразие размеров эритроцитов) | См. колонку «Возможные причины повышения» |
| Пониженные значения (<11.5%) | Обычно указывает на моноцитоз (преобладание эритроцитов одинакового размера) | Железодефицитная анемия на ранних стадиях, некоторые виды талассемии. |
Когда назначают анализ
Исследование осуществляется в рамках плановых медицинских осмотров, а также перед проведением хирургических вмешательств.
Анализ назначается для диагностики различных заболеваний. Пациенту рекомендуется пройти это исследование при наличии следующих симптомов:
- высокая температура без явных причин (при отсутствии других признаков болезни);
- снижение работоспособности;
- увеличение потоотделения;
- желтушность кожи и склер глаз;
- постоянная усталость;
- нарушения сна (например, сонливость в течение дня, несмотря на полноценный ночной отдых).
Если человек часто испытывает раздражительность, агрессию, апатию и усталость, а также замечает резкие изменения настроения, ему также следует пройти данное исследование.
Анализ помогает различать различные виды анемии и определить, какое лечение будет наиболее эффективным для каждого конкретного пациента.
Эта диагностика является обязательной для женщин во время беременности.
RDW, или индекс распределения эритроцитов, является важным показателем в анализе крови, который помогает врачам оценить состояние здоровья пациента. Многие люди не знают, что это за показатель и какую информацию он может предоставить. RDW измеряет вариацию размеров красных кровяных клеток, и его увеличение может указывать на различные заболевания, такие как анемия или дефицит витаминов. Некоторые пациенты отмечают, что их врачи объясняют значение RDW в контексте других анализов, что помогает лучше понять общее состояние организма. Важно помнить, что RDW не является самостоятельным диагнозом, а лишь одним из элементов, который помогает врачам составить полную картину здоровья. Люди часто делятся своим опытом, как результаты анализа RDW помогли выявить скрытые проблемы, что подчеркивает значимость регулярных медицинских обследований.
https://youtube.com/watch?v=U9_0SBEB248
Подготовка к исследованию
Для получения надежных и точных результатов анализа крайне важно следовать установленным рекомендациям по подготовке. Специалисты предлагают учитывать следующие советы:
- Кровь необходимо сдавать натощак. Время между последним приемом пищи и забором биоматериала должно составлять не менее восьми часов. Поэтому лучше всего проводить анализы в утренние часы.
- Накануне анализа следует избегать употребления алкогольных напитков.
- За несколько часов до процедуры рекомендуется не курить.
- За час до забора крови важно исключить физические и эмоциональные нагрузки. Непосредственно перед процедурой стоит провести в спокойствии хотя бы 15 минут.
- Если накануне были приняты какие-либо медикаменты, обязательно сообщите об этом лаборанту.
- После некоторых медицинских процедур, таких как ректальное обследование, рекомендуется подождать определенное время перед сдачей крови.
В некоторых медицинских учреждениях советуют взять с собой одноразовые стерильные перчатки и скарификатор, которые можно легко приобрести в аптеке.
Нормальные значения у мужчин и женщин
У взрослых уровень показателя в норме, как правило, остается стабильным.
https://youtube.com/watch?v=KSrjQV8v0fY
Норма RDW для лиц слабого пола
У женщин уровень составляет от 11,5% до 14,5%. Этот показатель может варьироваться во время беременности.
Норма для лиц сильного пола
Нормальный уровень RDW для мужчин составляет от 11,5% до 15%.
Норма при беременности
Во время беременности данный параметр необходимо регулярно отслеживать.
Как правило, у женщин в положении фиксируются пониженные значения. Это связано с изменениями в привычном гормональном фоне.
Нередко у беременных наблюдаются и повышенные показатели. Это представляет собой серьезную опасность, так как может свидетельствовать о наличии анемии.
Нормальное значение у детей
У младенцев уровень этого показателя значительно выше, чем у взрослых. Это связано с необходимостью адаптации к новым условиям жизни после рождения.
В норме у новорожденных процентное соотношение колеблется от 14,8 до 18,7. Со временем этот показатель начинает снижаться и достигает значений не выше 14,8 и не ниже 11,6 процентов. Примерно такой уровень фиксируется уже к полугоду жизни.
Причины отклонений в меньшую сторону
Низкие значения процентного соотношения размера эритроцитов следует рассматривать вместе с показателем MCV, который отражает средний объем эритроцитов.
Если RDW находится на низком уровне, а MCV, наоборот, высок, это может указывать на наличие онкологического процесса в костном мозге. В некоторых случаях это также может свидетельствовать о метастазах, которые распространились на данный орган.
Когда оба показателя имеют низкие значения, возможные причины могут быть связаны с заболеваниями селезёнки или печени.
Снижение среднего объема при нормальном RDW может быть вызвано следующими факторами:
- талассемия;
- гемотрансфузия;
- онкологические заболевания;
- кровотечения;
- период после химиотерапии.
Специалисты отмечают, что низкий уровень встречается довольно редко. Чаще всего такие результаты могут указывать на ошибки в проведении анализа или неправильную интерпретацию данных врачом.
Другими возможными причинами пониженного уровня данного показателя крови могут быть:
- послеоперационный период (например, после удаления части органа);
- гормональные изменения (половое созревание, климакс, беременность);
- нехватка витаминов группы В;
- дефицит фолиевой кислоты;
- кровопотери;
- нарушения обмена веществ.
Особенно опасны кровотечения из матки или желудка, так как они могут привести к быстрой потере крови, что часто сопровождается снижением рассматриваемого показателя.
Иногда уровень может понижаться, если человек сдавал кровь накануне. Отклонения в меньшую сторону также могут быть связаны с приемом некоторых медикаментов, например, оральных контрацептивов.
Нормализация пониженного уровня RDW
Для эффективного лечения данной патологии необходимо точно определить ее причину. В случае онкологического заболевания терапию назначает врач-онколог, основываясь на диагнозе, степени тяжести болезни и индивидуальных характеристиках пациента.
В зависимости от ситуации может быть рекомендовано хирургическое вмешательство, а также лучевая или химиотерапия.
Если в организме наблюдается нехватка определенных веществ, врач может прописать специальные медикаменты и витаминно-минеральные комплексы. Важно также следовать сбалансированному питанию, богатому необходимыми витаминами и минералами.
При изменениях в гормональном фоне, а также в случаях донорства и переливания крови специального лечения не требуется. Обычно показатели восстанавливаются самостоятельно со временем. Тем не менее, соблюдение правильного режима и диеты остается важным.
Почему диагностируется высокий показатель
На увеличение данного показателя могут указывать такие признаки, как периодически возникающая высокая температура, снижение работоспособности, повышенная сонливость и усиленное потоотделение.
Если RDW находится на повышенном уровне, это может свидетельствовать о наличии различных заболеваний в организме. К ним относятся:
- болезнь Альцгеймера;
- печеночная недостаточность;
- онкологические заболевания;
- сердечно-сосудистые патологии.
Причины повышения этого показателя могут быть связаны с алкогольной зависимостью, а также с нехваткой необходимых микро- и макроэлементов, витаминов. Часто высокие значения наблюдаются при дефиците железа, фолиевой кислоты и витамина В12.
Анемия различного происхождения также является важным фактором, способствующим увеличению показателя. Значения могут возрастать при микроцитарной, гемолитической, железодефицитной и мегалобластной анемии.
Как понизить уровень РДВ
Для того чтобы выяснить, как нормализовать этот показатель крови, врач должен направить пациента на дополнительные исследования.
После установления точного диагноза назначается соответствующее лечение.
В любом случае терапия должна быть комплексной, что включает использование определенных медикаментов и проведение физиотерапевтических процедур.
В некоторых случаях может потребоваться хирургическое вмешательство.
Таким образом, RDW представляет собой важный показатель, который способствует диагностике различных патологий в организме. Кроме того, он помогает определить тип анемии.
Вопрос-ответ
Что такое RDW и зачем он нужен в анализе крови?
RDW (Red Cell Distribution Width) — это показатель, который отражает вариацию размеров эритроцитов в крови. Он помогает врачам оценить, насколько однородны красные кровяные клетки. Изменения в RDW могут указывать на различные заболевания, такие как анемия или дефицит витаминов.
Каковы нормальные значения RDW в анализе крови?
Нормальные значения RDW обычно колеблются от 11,5% до 14,5%. Однако эти показатели могут варьироваться в зависимости от лаборатории и используемых методов. Важно интерпретировать результаты в контексте других анализов и клинической картины пациента.
Что может означать повышенный уровень RDW?
Повышенный уровень RDW может указывать на наличие различных заболеваний, таких как железодефицитная анемия, мегалобластная анемия или хронические воспалительные процессы. Это может также свидетельствовать о дефиците витаминов, таких как B12 или фолиевая кислота. Важно провести дополнительные исследования для точной диагностики.
Советы
СОВЕТ №1
Обратите внимание на значения RDW в контексте других показателей анализа крови. RDW (ширина распределения эритроцитов) может быть более информативным, если рассматривать его вместе с уровнем гемоглобина и количеством эритроцитов.
СОВЕТ №2
Если ваши показатели RDW выходят за пределы нормы, не паникуйте. Это может быть связано с различными факторами, такими как дефицит витаминов или хронические заболевания. Обсудите результаты с врачом для получения точной интерпретации.
СОВЕТ №3
Регулярно проходите медицинские обследования, чтобы отслеживать изменения в показателях крови, включая RDW. Это поможет выявить возможные проблемы на ранней стадии и своевременно принять меры.
СОВЕТ №4
Изучите, какие факторы могут влиять на уровень RDW, такие как питание, уровень физической активности и наличие хронических заболеваний. Здоровый образ жизни может помочь поддерживать нормальные показатели.